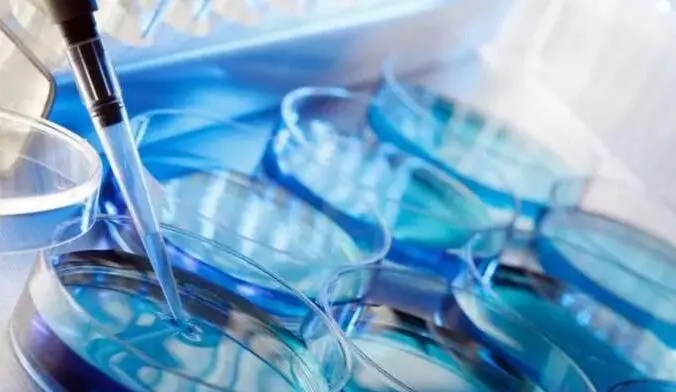

医院动态
热点资讯
孕17周可以吃菊花吗
有家健康网 2025-05-06阅读量:9974
孕妇在怀孕17周时可以适量食用菊花,但需要注意选择适合自己体质的方式和量,以避免不必要的健康风险。 菊花作为一种传统中药和食材,在适量使用的情况下,对大多数孕妇来说是安全的,并且具有一定的健康益处。
菊花的性质与功效:菊花性微寒,有疏散风热、清肝明目之效,对于缓解孕期上火引起的不适如头痛、眼睛干涩等有一定帮助。由于其寒性特质,脾胃虚寒的孕妇应当谨慎食用,以免引起肠胃不适或其他不良反应。
食用方式的选择:孕妇可以选择将菊花泡水饮用或加入菜肴中,但是要确保菊花来源的安全性,避免农药残留等问题。对于喜欢甜味的孕妇,可以用少量蜂蜜代替糖来调味,但要注意蜂蜜的添加量不宜过多,以防影响血糖水平。
注意事项:尽管菊花茶对许多孕妇有益,但并不是所有孕妇都适合饮用。例如,患有糖尿病或者脾胃虚寒的孕妇应该限制摄入量,避免过量饮用导致身体不适。初次尝试菊花制品的孕妇应留意自身反应,一旦出现过敏症状,应立即停止使用并咨询医生意见。
合理控制摄入量:即使是健康的孕妇也应遵循“适量”的原则,每日饮用菊花茶不应超过两杯,这样既能享受其带来的好处,又不会给身体带来负担。孕妇在孕期的不同阶段可能需要调整菊花的摄入量,特别是在孕早期,建议更加谨慎地考虑是否饮用菊花茶。
怀孕17周的女性可以在注意个人体质和菊花摄入量的前提下适量食用菊花。通过正确的选择和合理的食用方法,不仅可以享受到菊花带来的清凉感和健康益处,还能确保母婴的安全与健康。如果存在任何疑虑或特殊情况,孕妇应事先咨询医疗专业人士的意见。
联系我们
-
门诊时间(全年无休)8:00-20:00
-
医院地址:厦门市湖里区湖里大道37号







 胃部疾病
胃部疾病 肠道疾病
肠道疾病 胃肠症状
胃肠症状 就医指南
就医指南